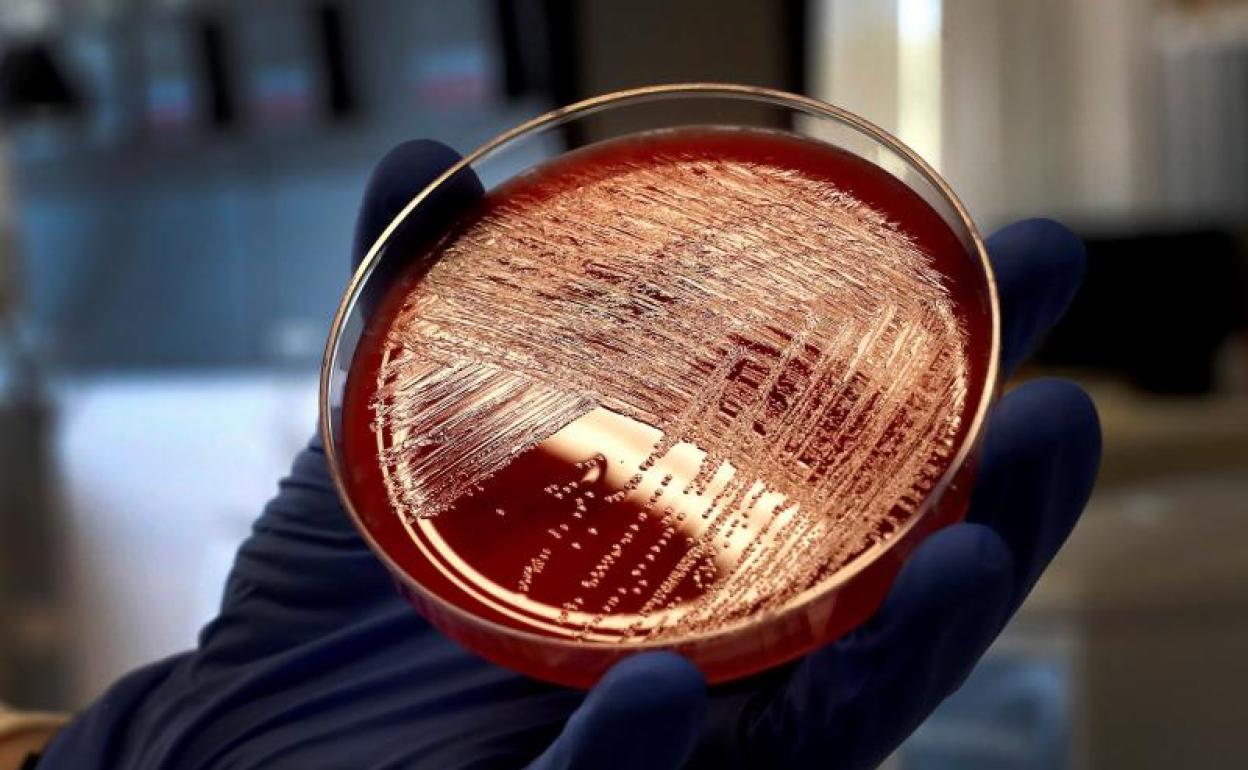
Vista de un cultivo de listeriosis.

Los últimos focos de listeria fueron alertas «habituales»
La Junta de Andalucía intenta rebajar la tensión y la alarma social ante el menor consumo de carne mechada o chicharrones
cecilia cuerdo
Sevilla
Viernes, 13 de septiembre 2019, 18:44
El ejecutivo andaluz desvinculó este viernes las dos nuevas alertas por listeriosis del brote detectado en la empresa sevillana Magrudis, que se salda ya con ... 215 afectados, 33 de los cuales continúan hospitalizados. En plena crisis del sector cárnico y con la bajada de consumo de carne mechada y embutidos cárnicos como los chicharrones, la Junta de Andalucía trata de rebajar la tensión y defiende que la alerta alimentaria de la pasada semana en la empresa Sabores de Paterna o la decretada este viernes en la empresa Incarybe S.L, que afectó a un consumidor, corresponden a avisos habituales de toxiinfección alimentaria en países occidentales.
El portavoz del gabinete de crisis para el brote de listeria, Jesús Cisneros, recordó que estas infecciones, al igual que otras contaminaciones alimentarias, no son infrecuentes. «Y es importante para entender en su justa medida la magnitud de las tres alertas», indicó. Al año se detectan una decena de alertas alimentarias por productos contaminados por listeria, por lo que la retirada de productos actúa de medida preventiva. O si se producen alertas sanitarias, como la de La Montanera del Sur, suelen tener un impacto limitado y pocos casos de infectados.
Por este motivo, el portavoz insistió en que la primera alerta, la decretada en agosto y vinculada a la firma sevillana Magrudis, se corresponde con «el único brote y es extraordinario por la cantidad de afectados«. La Junta se remite a los focos registrados en 2011 en Estados Unidos, que dejó menos pacientes aunque con una mayor tasa de mortalidad, o el más reciente de Sudáfrica, en 2017, que causó 1.060 casos registró una tasa de mortalidad del 27%.
En este sentido, insistió en que el brote «está en remisión desde el 23 de agosto», atribuyendo los casos que han ido apareciendo desde entonces al largo periodo de incubación de la bacteria. Asimismo, Cisneros subrayó que los resultados clínicos de los 215 pacientes infectados por el consumo de carne mechada La Mechá «están siendo mucho más favorables de lo esperado». Según las estimaciones del equipo científico al frente de la crisis, «se espera que el brote finalice en octubre», y hasta entonces el goteo de nuevos casos será cada vez menos significativo.
Pese a estos datos, desde Facua-Consumidores en Acción consideran que los tres casos detectados en menos de un mes demuestran que el actual sistema de autocontrol de las empresas cárnicas, basado en «declaraciones responsables o simples controles documentales», no funciona. Por eso, reclaman que «debe verse complementado con controles de las autoridades sanitarias realmente garantistas para evitar, como ha ocurrido en dos de las empresas, que sólo se detecte la contaminación cuando ya hay víctimas».
¿Tienes una suscripción? Inicia sesión